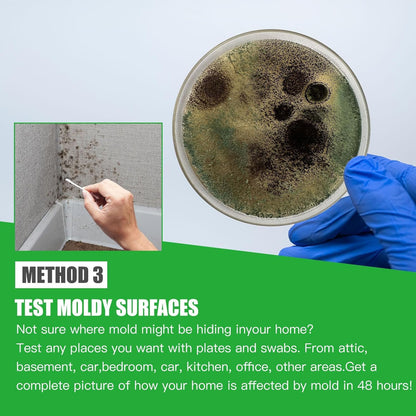
Mold Test Kit for Home Within 6 Individual Tests,DIY Detector at Home,Surface Mold,HVAC,Indoor Air Quality Testing Kits,Black Mold Testing,Includes Detailed Mold Identification Guide and Free Lab

Limited Stocks Only...
Limited Stocks Only...
Limited Stocks Only...
Limited Stocks Only...
Limited Stocks Only...
Limited Stocks Only...
Limited Stocks Only...
Limited Stocks Only...
Limited Stocks Only...
Limited Stocks Only...
Limited Stocks Only...
Limited Stocks Only...
Limited Stocks Only...
Limited Stocks Only...
Limited Stocks Only...
Limited Stocks Only...